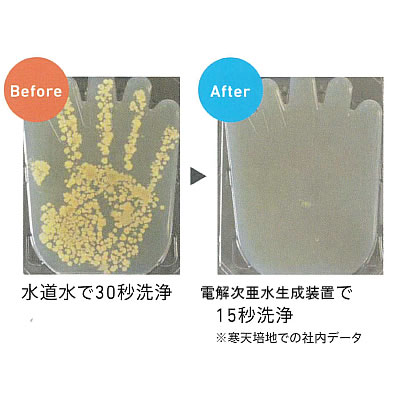

|
|
■包装資材 ■包装機械 ■物流機器 ■測定機器 ■洗剤 ■ケミカル ■蛍光灯 ■季節品-夏 ■季節品-冬 ■弱電工具 ■ホイスト ■環境機器 ■掃除機 ■ムーブテック ■切削工具 ■機械工具■調理厨房機器 ■研究室用品 ■安全防犯防災品 ■エクステリア ■新商品 ■在庫処分
| 電解次亜水生成装置(除菌殺菌水)/ 品番 M2642ME-18LK | 【詳細表示】 | ||||||||||||||||||||||||||||||||||||||||||||||||||||||||||||||||
| 商品番号 | M2642ME-18LK | 価 格 | |||||||||||||||||||||||||||||||||||||||||||||||||||||||||||||||
 |
電解次亜水生成装置(除菌殺菌水) 品番 M2642ME-18LK |
||||||||||||||||||||||||||||||||||||||||||||||||||||||||||||||||
| 食品添加物対応 HACCP対応 薬剤不要 低ランニングコスト 生成量:18㍑/分  ■安全・安心。食塩水からつくる、人・食材・環境に優しい殺菌洗浄水です。 食材に直接使用できる電解次亜水を水道水のように使って、様々なシーンで広範囲に食中毒対策・衛生管理にべ活用できます。 [電解次亜水]原料は、水・塩・電気のみからつくられる食材に直接使用できる、弱アルカリ性の除菌洗浄水です。 幼稚園、病院、老人ホーム、給食施設、レストラン、ホテル 等 ■装置  ■低ランニングコスト 18㍑/分の大生成量を実現 1㍑あたり0.3円と低ランニングコストのためトータルな衛生管理が可能です。 アメリカFDAでも食品添加物として認められています。 ※40mg/kg時の電気代、水道代、塩代含む ■操作パネル  ■簡単操作で3つのモード切り替え [連続生成]:先止め方式(水栓の開閉で生成/停止) [指定量生成]:設定された指定量を生成後停止 [自動貯水]:貯水タンクの水位により自動生成 ■イメージ図  ■連続式(先止め式)  ■指定量生成式/自動貯水式  ■殺菌効果 ■仕様
また、原水の物性により仕様を満足できない場合もあります。
|
|||||||||||||||||||||||||||||||||||||||||||||||||||||||||||||||||
運賃、および消費税は、記載価格には、含まれていません。

[トップページに戻る] [注文書] [見積り依頼] TEL 0729-64-8663 FAX 0729-61-4874
営業時間 AM9:00~PM7:00 営業日 月曜日~金曜日 定休日 土曜日 日曜日 祝日